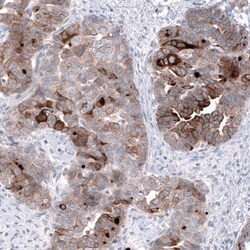
HE4/WFDC2 Antibody (CL12917) - Azide and BSA Free, Novus Biologicals 100

missing translation for 'onlineSavingsMsg'
Learn More
Learn More
HE4/WFDC2 Antibody (CL12917) - Azide and BSA Free, Novus Biologicals™
Mouse Monoclonal Antibody
Brand: Novus Biologicals NBP3-44175
This item is not returnable.
View return policy
Description
HE4/WFDC2 Monoclonal antibody specifically detects HE4/WFDC2 in Human samples. It is validated for Immunohistochemistry (Paraffin),Immunohistochemistry
Specifications
| HE4/WFDC2 | |
| Monoclonal | |
| LYOPH | |
| Immunohistochemistry-Paraffin 1:20 - 1:50 | |
| dJ461P17.6, EDDM4, Epididymal secretory protein E4, epididymis-specific, whey-acidic protein type, four-disulfide core, HE4MGC57529, Major epididymis-specific protein E4, Putative protease inhibitor WAP5, WAP domain containing protein HE4-V4, WAP four-disulfide core domain 2, WAP four-disulfide core domain protein 2, WAP5epididymal protein 4 | |
| This antibody was generated using a recombinant protein sequence of Q14508, with the exact immunogen sequence remaining proprietary. | |
| 100 μL | |
| Cancer | |
| 10406 | |
| Human | |
| Purified |
| Immunohistochemistry (Paraffin), Immunohistochemistry | |
| CL12917 | |
| Unconjugated | |
| Lyophilized in 5% Trehalose. | |
| Mouse | |
| Protein A purified | |
| RUO | |
| Primary | |
| Centrifuge the vial of lyophilized antibody at 12,000 x g for 20 seconds. Reconstitute by adding sterile, distilled water to achieve a final antibody concentration of 1mg/mL. | |
| Store at 4⪚C short term. Aliquot and store at -20⪚C long term. Avoid freeze-thaw cycles. | |
| IgG1 |
Product Content Correction
Your input is important to us. Please complete this form to provide feedback related to the content on this product.
Product Title
Spot an opportunity for improvement?Share a Content Correction